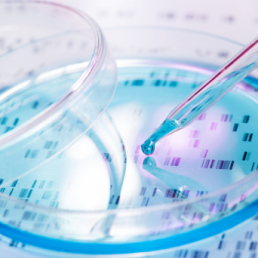
Genetic panels for hereditary cancers Predict&Prevent - 138 genes

- Medicover
- CC Hospital products
- Magnetic resonance imaging
- Comprehensive Health Screening
Comprehensive Health Screening
A one-day screening of your health in Medicover Hospital
Warszawa
Szpital Medicover
Selected location:
Szpital Medicover
The price includes all fees

What is Comprehensive Health Screening?
Our programme of Comprehensive Health Diagnostics is a unique offer on the Polish market allowing you to have a precise check-up and assessment of your health and the basic organs, such as the lungs, the liver, the kidneys, the pancreas, the brain, the spine, the joints, the heart, the thyroid all within just 8 hours.
Cutting-edge testing methods and state-of-the-art diagnostic apparatus make it possible to diagnose diseases even at their asymptomatic stage.
What do you get in the Comprehensive Health Screening?
Laboratory Tests – 30+ parameters
All key parameters in a single collection.Imaging and functional studies – 11 items
A set of tests tailored to gender and age (e.g. ultrasound, ECG/echo, spirometry – according to the package).Specialist consultations – 3 visits
Leading consultations + specialist consultations (selection according to indications)Report + action plan after the visit
You will leave with a ready-made "health map" for the coming months.
What is Comprehensive Health Screening?
is an in-depth and precise programme of diagnostic tests and examinations, offering a detailed check-up and assessment of your health within just 1 day. ZWe provide the most advanced diagnostic methods, amongst others, for:
- assessing the heart;
- assessing the coronary vessels;
- assessing the risk of stroke;
- assessing the risk of myocardial infarction;
- assessing the risk of atherosclerosis;
- assessing the risk of prostate cancer;
- assessing the testicles,
- assessing the thyroid.

Who should attend The Comprehensive Health Screening?
The programme of comprehensive diagnostic tests and examinations is designed for everybody who:
- wants to become familiar with a detailed assessment of his/her health;
- respects his/her time and wants to obtain comprehensive diagnosis;
- has a family history of cancers or cardiovascular diseases.
Early detection is the best prevention
In 70% of our Patients we detected the onsets of serious diseases, such as cancers or brain aneurysms. Thereby saving many patients’ lives.

What does the Comprehensive Health Screening include?
- Magnetic resonance imaging (MRI) of the entire body - allows for preliminary imaging screening. Its scope includes the whole body and gives an insight into the structures of the neurological, osteoarticular and muscular systems as well as most internal organs.
- Chest X-ray - assessment of the lungs and the cardiovascular system.
- Ultrasonography of the abdominal cavity - diagnosing abnormalities in the structure and function of organs in the abdominal cavity (including neoplastic lesions and cysts).
- Ultrasonography (Doppler) of the cervical arteries - assessment of artery stenosis and the risk of stroke.
- ECG / exercise test - assessment of the heart and coronary vessels. Detection of any irregularities in the structure and functions of the cardiac (heart) muscle
- Echocardiogram - assessment of cardiac anatomy and function.
- Spirometry - assessment of the respiratory system.
- Breast ultrasound - early detection of neoplastic lesions.
- Ultrasonography of the urogenital organs – assessment of the urogenital system. In males – the assessment of prostate and testicular cancer.
- Ultrasonography of the thyroid gland - size, shape, position and morphological evaluation
- Blood test and urine analysis (basic and advanced) - detection of numerous diseases: anaemia, cancers and precancerous conditions of the blood and bone marrow, all types of inflammations, including those posing the risk of cardiovascular diseases, abnormalities in kidney functions, arterial hypertension and diabetes.
- Faecal tests - assessment of pathologies in the gastrointestinal tract
- Lipid profile - determining the risk of stroke, myocardial infarction and vascular diseases.
- Serological tests - detection of asymptomatic, viral infections of the liver.
- Female genetic testing - assessment of inborn predispositions to breast, ovarian and cervical cancers.
Comprehensive health check-up at the Medicover Hospital in Warsaw
Over 70% of deaths in Poland are caused by diseases of the circulatory system and cancers, which are primarily targeted by the Comprehensive Health Screening.
It is important to realise that today a number of serious diseases can be diagnosed at an early stage. This is possible thanks to highly sensitive and state-of-the-art apparatus that allows for diagnosing diseases even before they start to produce any symptoms. This provides a huge opportunity for a given disease to be completely cured.
What does the Comprehensive Health Screening include?
- Magnetic resonance imaging (MRI) of the entire body - allows for preliminary imaging screening. Its scope includes the whole body and gives an insight into the structures of the neurological, osteoarticular and muscular systems as well as most internal organs.
- Chest X-ray - assessment of the lungs and the cardiovascular system.
- Ultrasonography of the abdominal cavity - diagnosing abnormalities in the structure and function of organs in the abdominal cavity (including neoplastic lesions and cysts).
- Ultrasonography (Doppler) of the cervical arteries - assessment of artery stenosis and the risk of stroke.
- ECG / exercise test - assessment of the heart and coronary vessels. Detection of any irregularities in the structure and functions of the cardiac (heart) muscle
- Echocardiogram - assessment of cardiac anatomy and function.
- Spirometry - assessment of the respiratory system.
- Breast ultrasound - early detection of neoplastic lesions.
- Ultrasonography of the urogenital organs – assessment of the urogenital system. In males – the assessment of prostate and testicular cancer.
- Ultrasonography of the thyroid gland - size, shape, position and morphological evaluation
- Blood test and urine analysis (basic and advanced) - detection of numerous diseases: anaemia, cancers and precancerous conditions of the blood and bone marrow, all types of inflammations, including those posing the risk of cardiovascular diseases, abnormalities in kidney functions, arterial hypertension and diabetes.
- Faecal tests - assessment of pathologies in the gastrointestinal tract
- Lipid profile - determining the risk of stroke, myocardial infarction and vascular diseases.
- Serological tests - detection of asymptomatic, viral infections of the liver.
- Female genetic testing - assessment of inborn predispositions to breast, ovarian and cervical cancers.
Ważne informacje:
- The screening service may be provided within three (3) months from its purchase (starting from the date indicated in the order confirmation).
- Please contact the hotline of Medicover Multidisciplinary Hospital by phone at +48 500 900 902
- The screening service is provided in Medicover Hospital in Warsaw.
- Out of concern for the quality of your results, we kindly ask you to adequately prepare for the tests/examinations. Precise information on how to do it is available in the “Documents” tab.
- For some patients Magnetic Resonance Imaging (MRI) is not recommended – please read more about the contraindications HERE.
Others also bought
Comprehensive panel to assess predisposition to cancers of multiple organs due to genetic causes. The panel includes 54 genes. The test requires a blood sample.

Take advantage of comprehensive health sreening for women. Within 1 day, the most important tests for your health will be done, such as ultrasound, x-ray, ekg and much more. Check in Medistore

Take advantage of comprehensive health sreening for men. Within 1 day, the most important tests for your health will be done, such as ultrasound, x-ray, ekg and much more. Check in Medistore